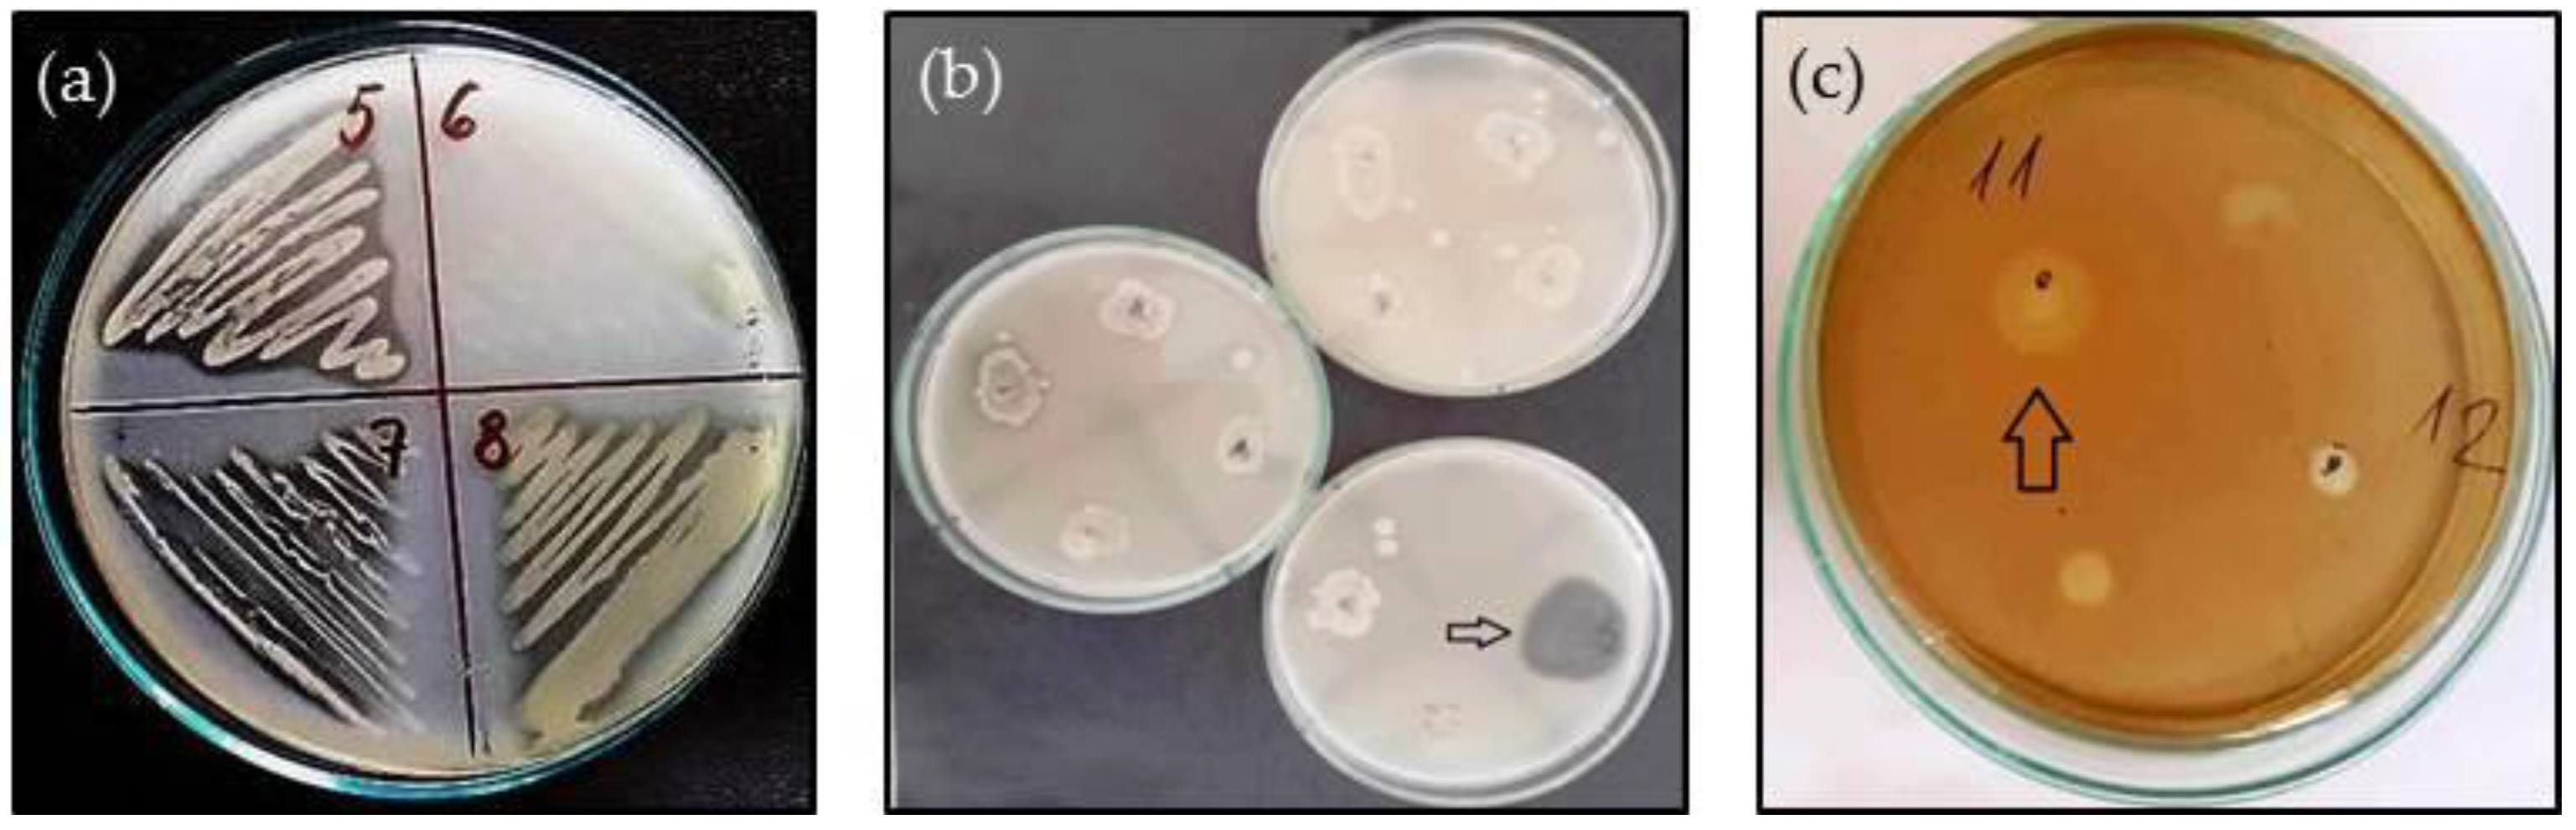
Life 14 00566 g001 Life 14 00566 g001

Pathogenic Potential of Opportunistic Gram-Negative Bacteria Isolated from the Cloacal Microbiota of Free-Living Reptile Hosts Originating from Bulgaria
Abstract
1. Introduction
2. Materials and Methods
2.1. Sample Collection
2.2. Isolation and Identification of Microorganisms
2.3. Antimicrobial Susceptibility Testing (AST)
2.4. Estimation of Enzymatic Activity
2.5. Biofilm Formation
3. Results
3.1. Antibiotic Susceptibility
3.2. Extracellular Enzyme Production
3.3. Biofilm-Forming Capacity
| Bacterial Isolates | A. Antibiotics | B. Extracellular Enzyme Production | C. Biofilm- | |||||||||||
|---|---|---|---|---|---|---|---|---|---|---|---|---|---|---|
| A | Am | C | Cp | Cfz | G | Tb | T | Sial | Prot | Lip | Gel | Hyal | ||
| from lizards | ||||||||||||||
| H. alvei | S | S | S | S | R | S | S | S | − | − | − | − | − | ++ |
| E. amnigenus | R | S | S | S | S | S | S | S | − | + | − | − | − | +++ |
| E. cloacaeL | S | S | S | S | S | S | S | S | − | + | − | − | − | ++ |
| E. nimipressuralis | S | S | S | S | S | S | S | S | − | − | − | − | − | ++ |
| C. braakiiL | S | S | S | S | S | S | S | S | + | + | − | − | − | +++ |
| C. youngae | I | S | S | S | I | S | S | S | − | + | − | − | − | +++ |
| C. freundii | S | S | S | S | S | S | S | S | + | + | − | − | − | +++ |
| C. werkmanii | S | S | S | S | I | S | S | S | − | + | − | − | − | +++ |
| P. aeruginosa | R | S | S | S | R | S | S | R | − | + | + | + | − | ++++ |
| R. aquatilisL | I | S | S | S | I | S | S | S | − | + | − | − | − | ++ |
| K. oxytocaL | R | S | S | S | S | S | S | S | − | + | − | − | − | ++++ |
| Buttiauxella sp. | S | S | S | S | S | S | S | S | − | − | − | − | − | ++ |
| V. metschnikovii | S | S | S | S | S | S | S | S | − | − | − | + | − | + |
| E. vulneris | S | S | S | S | R | S | S | S | − | − | − | − | − | ++ |
| E. coli | S | S | S | S | S | S | S | S | − | + | − | − | − | +++ |
| S. plymuthica | S | S | S | S | I | S | S | S | + | + | − | − | − | ++ |
| P. heimbachae | S | S | S | S | S | S | S | S | − | − | − | − | + | + |
| R. terrigena | S | S | S | S | S | R | R | S | − | + | − | + | − | + |
| from tortoises | ||||||||||||||
| C. braakiiL | S | S | S | S | I | S | S | nd | − | + | − | − | − | ++ |
| E. cloacaeL | S | S | S | S | I | S | S | nd | − | + | − | − | − | +++ |
| K. oxytocaL | S | S | S | S | S | S | S | nd | − | + | − | − | − | ++ |
| K. pneumoniae | R | S | S | S | S | S | S | nd | − | + | − | − | − | +++ |
| K. aerogenes | S | S | S | S | R | S | S | nd | − | + | − | − | − | + |
| S. enterica | S | S | S | S | S | S | S | nd | − | + | − | − | − | ++ |
| R. aquatilisL | I | S | S | S | S | S | S | nd | + | + | − | − | − | + |
| M. morganii | S | S | I | S | I | S | S | nd | − | + | − | − | − | + |
| P. agglomerans | S | S | S | S | S | S | S | nd | − | + | − | − | − | ++ |
4. Discussion
5. Conclusions
Author Contributions
Funding
Institutional Review Board Statement
Data Availability Statement
Conflicts of Interest
References
- Ebani, V.; Fratini, F. Bacterial zoonozes among domestic reptiles. Annali. Fac. Med. Vet. 2005, 26, 85–91. [Google Scholar]
- Marenzoni, M.; Stefanetti, V.; Del Rossi, E.; Zicavo, A.; Scuota, S.; Origgi, F.; Deli, G.; Corti, C.; Marinucci, M.; Olivieri, O. Detection of Testudinid alphaherpesvirus, Chlamydia spp., Mycoplasma spp. and Salmonella spp. in free-ranging and rescued Italian Testudo hermanni hermanni. Vet. Ital. 2022, 58, 25–34. [Google Scholar] [CrossRef] [PubMed]
- Krautwald-Junghanns, M.; Stenkat, J.; Szabo, I.; Ortlieb, F.; Blindow, I.; Neul, A.; Pees, M.; Schmidt, V. Characterization of Salmonella isolated from captive and free-living snakes in Germany. Berl. Munch. Tierarztl. Wochenschr. 2013, 126, 209–215. [Google Scholar] [CrossRef] [PubMed]
- Pees, M.; Rabsch, W.; Plenz, B.; Fruth, A.; Prager, R.; Simon, S.; Schmidt, V.; Munch, S.; Braun, P. Evidence for the transmission of Salmonella from reptiles to children in Germany, July 2010 to October 2011. Euro Surveill. 2013, 18, 20634. [Google Scholar] [CrossRef] [PubMed]
- Ebani, V. Domestic reptiles as source of zoonotic bacteria: A mini review. Asian Pac. J. Trop. Med. 2017, 10, 723–728. [Google Scholar] [CrossRef] [PubMed]
- Rodrigues, T.; Santos, A.; Lima, A.; Gomes, D.; Brites, V. Anti-Leptospira spp. antibodies in Crotalus durissus collilineatus kept in captivity and its zoonotic relevance. Acta Trop. 2016, 158, 39–42. [Google Scholar] [CrossRef] [PubMed]
- Sala, A.; Di Ianni, F.; Pelizzone, I.; Bertocchi, M.; Santospirito, D.; Rogato, F.; Flisi, S.; Spadini, C.; Lemmi, T.; Moggia, E.; et al. The prevalence of Pseudomonas aeruginosa and multidrug resistant Pseudomonas aeruginosa in healthy captive ophidian. PeerJ. 2019, 7, e6706. [Google Scholar] [CrossRef] [PubMed]
- Laroucau, K.; Ortega, N.; Vorimore, F.; Aaziz, R.; Mitura, A.; Szymanska-Czerwinska, M.; Cicerol, M.; Salinas, J.; Sachse, K.; Caro, M. Detection of a novel Chlamydia species in captive spur-thighed tortoises (Testudo graeca) in southeastern Spain and proposal of Candidatus Chlamydia testudinis. Syst. Appl. Microbiol. 2020, 43, 126071. [Google Scholar] [CrossRef] [PubMed]
- Guz, L.; Nowakiewicz, A.; Puk, K.; Zieba, P.; Gnat, S.; Matuszewski, L. Virulence and Antimicrobial Resistance Pattern of Aeromonas spp. Colonizing European Pond Turtles Emys orbicularis and Their Natural Environment. First Study from Poland. Animals 2021, 11, 2772. [Google Scholar] [CrossRef]
- Ollé, R.; Sevilla, I.; Juan-Sallés, C.; Garrido, J.; Santamaría, J. Mycobacterial Cloacitis with Systemic Dissemination in a Hermann’s Tortoise (Testudo hermanni). J. Herpetol. Med. Surg. 2022, 32, 162–170. [Google Scholar] [CrossRef]
- Romero, S.; Čížek, A.; Masaříková, M.; Knotek, Z. Choanal and cloacal aerobic bacterial flora in captive green iguanas: A comparative analysis. Acta Vet. Brno 2015, 84, 19–24. [Google Scholar] [CrossRef]
- Hossain, S.; Heo, G. Pet-turtles: A potential source of human pathogenic bacteria. Arch. Microbiol. 2021, 203, 3785–3792. [Google Scholar] [CrossRef]
- Dec, M.; Zajac, M.; Puchalski, A.; Szczepaniak, K.; Urban-Chmiel, R. Pet Reptiles in Poland as a Potential Source of Transmission of Salmonella. Pathogens 2022, 11, 1125. [Google Scholar] [CrossRef] [PubMed]
- Divers, S. Bacterial Diseases of Reptiles. In MSD Veterinary Manual; 2022; Available online: https://www.msdvetmanual.com/exotic-and-laboratory-animals/reptiles/bacterial-diseases-of-reptiles (accessed on 22 February 2024).
- Hacioglu, N.; Dulger, B.; Caprazli, T.; Tosunoglu, M. A study on microflora in oral and cloacal of freshwater turtles (Emys orbicularis Linnaeus, 1758 and Mauremys rivulata Valenciennes, 1833) from Kavak delta (Canakkale). Fresen. Environ. Bull. 2012, 21, 3365–3369. [Google Scholar]
- Schmidt, V.; Mock, R.; Burgkhardt, E.; Junghanns, A.; Ortlieb, F.; Szabo, I.; Marschang, R.; Blindow, I.; Krautwald-Junghanns, M. Cloacal aerobic bacterial flora and absence of viruses in free-living slow worms (Anguis fragilis), grass snakes (Natrix natrix) and European Adders (Vipera berus) from Germany. EcoHealth 2014, 11, 571–580. [Google Scholar] [CrossRef] [PubMed]
- Nowakiewicz, A.; Ziółkowska, G.; Zięba, P.; Dziedzic, B.; Gnat, S.; Wójcik, M.; Dziedzic, R.; Kostruba, A. Aerobic bacterial microbiota isolated from the cloaca of the European pond turtle (Emys orbicularis) in Poland. J. Wild Dis. 2015, 51, 255–259. [Google Scholar] [CrossRef] [PubMed]
- Lukač, M.; Tomić, D.; Mandac, Z.; Mihoković, S.; Prukner-Radovčić, E. Oral and cloacal aerobic bacterial and fungal flora of free-living four-lined snakes (Elaphe quatuorlineata) from Croatia. Vet. Arh. 2017, 87, 351–361. [Google Scholar] [CrossRef]
- Pawlak, A.; Morka, K.; Bury, S.; Antoniewicz, Z.; Wzorek, A.; Cieniuch, G.; Korzeniowska-Kowal, A.; Cichoń, M.; Bugla-Płoskońska, G. Cloacal Gram-Negative Microbiota in Free-Living Grass Snake Natrix natrix from Poland. Curr. Microbiol. 2020, 77, 2166–2171. [Google Scholar] [CrossRef]
- Piasecki, T.; Chrząstek, K.; Wieliczko, A. Salmonella serovar spectrum associated with reptiles in Poland. Acta Vet. Brno 2014, 83, 287–294. [Google Scholar] [CrossRef]
- Dudek, K.; Koczura, R.; Dudek, M.; Sajkowska, Z.; Ekner-Grzyb, A. Detection of Salmonella enterica in a sand lizard (Lacerta agilis, Linnaeus, 1758) city population. Herpetol. J. 2016, 26, 57–60. [Google Scholar]
- Zając, M.; Wasyl, D.; Różycki, M.; Bilska-Zając, E.; Fafński, Z.; Iwaniak, W.; Krajewska, M.; Hoszowski, A.; Fafńska, P.; Szulowski, K. Free-living snakes as a source and possible vector of Salmonella spp. and parasites. Eur. J. Wildl. Res. 2016, 62, 161–166. [Google Scholar] [CrossRef]
- Traving, C.; Schauer, R. Structure, function and metabolism of sialic acids. Cell. Mol. Life Sci. 1998, 54, 1330–1349. [Google Scholar] [CrossRef] [PubMed]
- Dogru, N.; Gul, C.; Tosunoglu, M. Some virulence factors of Gram negative bacteria isolated from some amphibian and reptilian species of the Biga stream in Turkey. Am. J. Innov. Res. Appl. Sci. 2018, 6, 29–34. [Google Scholar]
- Cota, J.B.; Carvahlo, A.C.; Dias, I.; Reisinho, A.; Bernardo, F.; Oliveira, M. Salmonella spp. in pet reptiles in Portugal: Prevalence and chlorhexidine gluconate antimicrobial efficacy. Antibiotics 2021, 10, 324. [Google Scholar] [CrossRef] [PubMed]
- Galgano, M.; Mrenoshki, D.; Pellegrini, F.; Capozzi, L.; Cordisco, M.; Del Sambro, L.; Trotta, A.; Camero, M.; Tempesta, M.; Buonavoglia, D.; et al. Antibacterial and biofilm production inhibition activity of Thymus vulgaris L. essential oil against Salmonella spp. isolates from reptiles. Pathogens 2023, 12, 804. [Google Scholar] [CrossRef] [PubMed]
- Hudzicki, J. Kirby-Bauer Disk Diffusion Susceptibility Test Protocol, American Society for Microbiology, 2009. Available online: https://asm.org/getattachment/2594ce26-bd44-47f6-8287-0657aa9185ad/Kirby-Bauer-Disk-Diffusion-Susceptibility-Test-Protocol-pdf.pdf (accessed on 24 November 2023).
- CLSI Guidelines M100—M02. Performance Standards for Antimicrobial Susceptibility Testing, 28th ed.; Clinical Laboratory Standards Institute: Wayne, PA, USA, 2018.
- The European Committee on Antimicrobial Susceptibility Testing (EUCAST), Breakpoint Tables for Interpretation of MICs and Zone Diameters, Version 14.0, 2024. Available online: http://www.eucast.org (accessed on 14 February 2024).
- Krumperman, P.H. Multiple antibiotic resistance indexing of Escherichia coli to identify high-risk sources of fecal contamination of foods. Appl. Environ. Microbiol. 1983, 46, 165–170. [Google Scholar] [CrossRef] [PubMed]
- dela Cruz, T.; Torres, J. Gelatin Hydrolysis Test Protocol, American Society for Microbiology, 2012. Available online: https://asm.org/ASM/media/Protocol-Images/Gelatin-Hydrolysis-Test-Protocol.pdf?ext=.pdf (accessed on 15 November 2023).
- Uchida, Y.; Tsukada, Y.; Sugimori, T. Distribution of neuraminidase in Arthrobacter and its purification by affinity chromatography. J. Biochem. 1977, 82, 1425–1433. [Google Scholar] [CrossRef]
- Patil, S.; Chaudhari, B. A simple, rapid and sensitive plate assay for detection of microbial hyaluronidase activity. J. Basic Microbiol. 2017, 57, 358–361. [Google Scholar] [CrossRef] [PubMed]
- Singh, B.; Singh, V.; Ebibeni, N.; Singh, R. Antimicrobial and herbal drug resistance in enteric bacteria isolated from faecal droppings of common house lizard/gecko (Hemidactylus frenatus). Int. J. Microbiol. 2013, 2013, 340848. [Google Scholar] [CrossRef]
- Laborda, P.; Sanz-García, F.; Ochoa-Sánchez, L.; Gil-Gil, T.; Hernando-Amado, S.; Martínez, J. Wildlife and antibiotic resistance. Front. Cell. Infec. Microbiol. 2022, 12, 873989. [Google Scholar] [CrossRef]
- Artavia-León, A.; Romero-Guerrero, A.; Sancho-Blanco, C.; Rojas, N.; Umaña-Castro, R. Diversity of aerobic bacteria isolated from oral and cloacal cavities from free-living snakes species in Costa Rica rainforest. Int. Sch. Res. Not. 2017, 2017, 8934285. [Google Scholar] [CrossRef] [PubMed]
- Afunwa, R.A.; Ezeanyinka, J.; Afunwa, E.C.; Udeh, A.S.; Oli, N.A.; Unachukwu, M. Multiple Antibiotic Resistant Index of Gram-Negative Bacteria from Bird Droppings in Two Commercial Poultries in Enugu, Nigeria. Open J. Med. Microbiol. 2020, 10, 171–181. [Google Scholar] [CrossRef]
- Barbour, E.; Chacra, N.; Gali-Mouhtaseb, H.; Jaber, L.; Nehme, P.; Shaib, H.; Sadek, R.; Usayran, N. Performance, bacterial shedding and microbial drug resistance in two tortoise species. Vet. Rec. 2007, 161, 62–64. [Google Scholar] [CrossRef] [PubMed]
- Morita, Y.; Tomida, J.; Kawamura, Y. Responses of Pseudomonas aeruginosa to antimicrobials. Front. Microbiol. 2014, 4, 422. [Google Scholar] [CrossRef] [PubMed]
- Lekhniuk, N.; Fesenko, U.; Pidhirnyi, Y.; Sękowska, A.; Korniychuk, O.; Konechnyi, Y. Raoultella terrigena: Current state of knowledge, after two recently identified clinical cases in Eastern Europe. Clin. Case Rep. 2021, 9, e04089. [Google Scholar] [CrossRef] [PubMed]
- Ruzauskas, M.; Misyte, S.; Vaskeviciute, L.; Mikniene, Z.; Siugzdiniene, R.; Klimiene, I.; Pikuniene, A.; Kucinskiene, J. Gut microbiota isolated from the European pond turtle (Emys orbicularis) and its antimicrobial resistance. Pol. J. Vet. Sci. 2016, 19, 723–730. [Google Scholar] [CrossRef][Green Version]
- Zajac, M.; Skarzynska, M.; Lalak, A.; Kwit, R.; Smialowska-Weglinska, A.; Pasim, P.; Szulowski, K.; Wasyl, D. Salmonella in captive reptiles and their environment—Can we tame the dragon? Microorganisms 2021, 9, 1012. [Google Scholar] [CrossRef] [PubMed]
- Marin, C.; Lorenzo-Rebenaque, L.; Laso, O.; Villora-Gonzalez, J.; Vega, S. 2021. Pet reptiles: A potential source of transmission of multidrug-resistant Salmonella. Front. Vet. Sci. 2021, 7, 613718. [Google Scholar] [CrossRef] [PubMed]
- Casalino, G.; Bellati, A.; Pugliese, N.; Camarda, A.; Faleo, S.; Lombardi, R.; Occhiochiuso, G.; Circella, E.; D’Onghia, F. Salmonella infection in turtles: A risk for staff Involved in wildlife management? Animals 2021, 11, 1529. [Google Scholar] [CrossRef]
- Sangeetha, A.; Abdel-hadi, A.; Hassan, A.; Shobana, C.; Suresh, S.; Abirami, B.; Selvam, K.; Al-Baradie, R.; Banawas, S.; Alaidarous, M.; et al. Evaluation of in vitro activities of extracellular enzymes from Aspergillus species isolated from corneal ulcer/keratitis. Saudi J. Biol. Sci. 2020, 27, 701–705. [Google Scholar] [CrossRef]
- Lantz, M. Are Bacterial proteases important virulence factors? J. Periodontal Res. 1997, 32, 126–132. [Google Scholar] [CrossRef] [PubMed]
- Figaj, D.; Ambroziak, P.; Przepiora, T.; Skorko-Glonek, J. The role of proteases in the virulence of plant pathogenic bacteria. Int. J. Mol. Sci. 2019, 20, 672. [Google Scholar] [CrossRef] [PubMed]
- Zhigis, L.; Kotelnikova, O.; Zinchenko, A.; Karlinsky, D.; Prokopenko, Y.; Rumsh, L. IgA1 protease as a vaccine basis for prevention of bacterial meningitis. Russ. J. Bioorg. Chem. 2021, 47, 805–814. [Google Scholar] [CrossRef]
- Juge, N.; Tailford, L.; Owen, C. Sialidases from gut bacteria: A mini-review. Biochem. Soc. Trans. 2016, 44, 166–175. [Google Scholar] [CrossRef] [PubMed]
- Jaeger, K.; Ransac, S.; Dijkstra, B.; Colson, C.; van Heuvel, M.; Misset, O. Bacterial lipases. FEMS Microbiol. Rev. 1994, 15, 29–63. [Google Scholar] [CrossRef] [PubMed]
- Costa, R.; Amorim, L.; Araújo, R.; dos Fernandes Vieira, R. Multiple enzymatic profiles of Vibrio parahaemolyticus strains isolated from oysters. Rev. Argent. Microbiol. 2013, 45, 267–270. [Google Scholar] [CrossRef] [PubMed]
- Bender, J.; Flieger, A. Lipases as pathogenicity factors of bacterial pathogens of humans. In Handbook of Hydrocarbon and Lipid Microbiology; Timmis, K.M., Ed.; Springer: Berlin/Heidelberg, Germany, 2010; pp. 3241–3258. [Google Scholar] [CrossRef]
- Starr, C.; Engleberg, N. Role of hyaluronidase in subcutaneous spread and growth of group A Streptococcus. Infect. Immun. 2006, 74, 40–48. [Google Scholar] [CrossRef]
- Damyanova, T.; Dimitrova, P.; Borisova, D.; Topouzova-Hristova, T.; Haladjova, E.; Paunova-Krasteva, T. An overview of biofilm-associated infections and the role of phytochemicals and nanomaterials in their control and prevention. Pharmaceutics 2024, 16, 162. [Google Scholar] [CrossRef]
- Stewart, P. 2002. Mechanisms of antibiotic resistance in bacterial biofilms. Int. J. Med. Microbiol. 2002, 292, 107–113. [Google Scholar] [CrossRef]

| Bacterial Species | Total Number of Positive Individuals/ Percentage | Hosts/Number of Positive Individuals | Number of Strains | ||
|---|---|---|---|---|---|
| Lizards n = 86 | |||||
| Hafnia alvei | 34 (39.5%) | L. viridis/5 A. kitaibelii/15 | P. muralis/5 A. fragilis/1 | D. praticola/8 | 5 |
| Enterobacter amnigenus biovar 2 | 30 (34.9%) | L. viridis/1 A. kitaibelii/10 | P. muralis/5 A. fragilis/1 | D. praticola/13 | 4 |
| Enterobacter cloacaeL | 11 (12.8%) | P. muralis/7 | D. praticola/4 | 2 | |
| Enterobacter nimipressuralis | 2 (2.3%) | P. muralis/2 | 1 | ||
| Citrobacter braakiiL | 28 (32.5%) | L. viridis/4 A. kitaibelii/3 | P. muralis/9 A. fragilis/1 | D. praticola/11 | 4 |
| Citrobacter youngae | 16 (18.6%) | L. viridis/3 A. kitaibelii/1 | P. muralis/7 A. fragilis/1 | D. praticola/4 | 2 |
| Citrobacter freundii | 10 (11.6%) | L. viridis/2 A. kitaibelii/4 | P. muralis/1 | D. praticola/3 | 3 |
| Citrobacter werkmanii | 1 (1.2%) | L. viridis/1 | 1 | ||
| Pseudomonas aeruginosa | 24 (27.9%) | L. viridis/1 A. kitaibeli/4 | P. muralis/8 A. fragilis/2 | D. praticola/9 | 5 |
| Rahnella aquatilisL | 22 (25.6%) | L. viridis/2 A. fragilis/1 | P. muralis/4 | D.praticola/15 | 6 |
| Klebsiella oxytocaL | 18 (20.9%) | L. viridis/6 A. kitaibelii/3 | P. muralis/2 A. fragilis/1 | D. praticola/6 | 5 |
| Buttiauxella sp. | 16 (18.6%) | P. muralis/4 | D.praticola/11 | A. kitaibelii/1 | 2 |
| Vibrio metschnikovii | 13 (15.1%) | D. praticola/7 | A. kitaibelii/6 | 1 | |
| Escherichia vulneris | 10 (11.6%) | L. viridis/2 | D. praticola/5 | A. kitaibelii/3 | 1 |
| Escherichia coli | 4 (4.6%) | L. viridis/2 | P. muralis/2 | 2 | |
| Serratia plymuthica | 9 (10.5%) | L. viridis/1 | P. muralis/3 | A. kitaibelii/5 | 2 |
| Providencia heimbachae | 4 (4.6%) | L. viridis/2 | D. praticola/2 | 1 | |
| Raoultella terrigena | 1 (1.2%) | L. viridis/1 | 1 | ||
| Total number of isolates | 253 | Total number of strains | 48 | ||
| Tortoises n = 24 | |||||
| Citrobacter braakiiT | 21 (87.5%) | T. graeca/10 | T. hermanni/11 | 3 | |
| Enterobacter cloacaeT | 19 (79.2%) | T. graeca/8 | T. hermanni/11 | 2 | |
| Klebsiella oxytocaT | 19 (79.2%) | T. graeca/10 | T. hermanni/9 | 3 | |
| Klebsiella pneumoniae | 19 (79.2%) | T. graeca/10 | T. hermanni/9 | 3 | |
| Klebsiella aerogenes | 13 (54.2%) | T. graeca/8 | T. hermanni/5 | 3 | |
| Salmonella enterica subsp. enterica | 18 (75%) | T. graeca/11 | T. hermanni/7 | 2 | |
| Rahnella aquatilisT | 17 (70.1%) | T. graeca/9 | T. hermanni/8 | 2 | |
| Morganella morganii | 7 (29.2%) | T. graeca/2 | T. hermanni/6 | 1 | |
| Pantoaea agglomerans | 5 (20.1%) | T. graeca/4 | T. hermanni/1 | 1 | |
| Total number of isolates | 138 | Total number of strains | 20 | ||
Disclaimer/Publisher’s Note: The statements, opinions and data contained in all publications are solely those of the individual author(s) and contributor(s) and not of MDPI and/or the editor(s). MDPI and/or the editor(s) disclaim responsibility for any injury to people or property resulting from any ideas, methods, instructions or products referred to in the content. |
© 2024 by the authors. Licensee MDPI, Basel, Switzerland. This article is an open access article distributed under the terms and conditions of the Creative Commons Attribution (CC BY) license (https://creativecommons.org/licenses/by/4.0/).
Share and Cite
Lazarkevich, I.; Engibarov, S.; Mitova, S.; Popova, S.; Vacheva, E.; Stanchev, N.; Eneva, R.; Gocheva, Y.; Lalovska, I.; Paunova-Krasteva, T.; et al. Pathogenic Potential of Opportunistic Gram-Negative Bacteria Isolated from the Cloacal Microbiota of Free-Living Reptile Hosts Originating from Bulgaria. Life 2024, 14, 566. https://doi.org/10.3390/life14050566
Lazarkevich I, Engibarov S, Mitova S, Popova S, Vacheva E, Stanchev N, Eneva R, Gocheva Y, Lalovska I, Paunova-Krasteva T, et al. Pathogenic Potential of Opportunistic Gram-Negative Bacteria Isolated from the Cloacal Microbiota of Free-Living Reptile Hosts Originating from Bulgaria. Life. 2024; 14(5):566. https://doi.org/10.3390/life14050566
Chicago/Turabian StyleLazarkevich, Irina, Stephan Engibarov, Simona Mitova, Steliyana Popova, Emiliya Vacheva, Nikola Stanchev, Rumyana Eneva, Yana Gocheva, Iva Lalovska, Tsvetelina Paunova-Krasteva, and et al. 2024. "Pathogenic Potential of Opportunistic Gram-Negative Bacteria Isolated from the Cloacal Microbiota of Free-Living Reptile Hosts Originating from Bulgaria" Life 14, no. 5: 566. https://doi.org/10.3390/life14050566
APA StyleLazarkevich, I., Engibarov, S., Mitova, S., Popova, S., Vacheva, E., Stanchev, N., Eneva, R., Gocheva, Y., Lalovska, I., Paunova-Krasteva, T., Ilieva, Y., & Najdenski, H. (2024). Pathogenic Potential of Opportunistic Gram-Negative Bacteria Isolated from the Cloacal Microbiota of Free-Living Reptile Hosts Originating from Bulgaria. Life, 14(5), 566. https://doi.org/10.3390/life14050566

